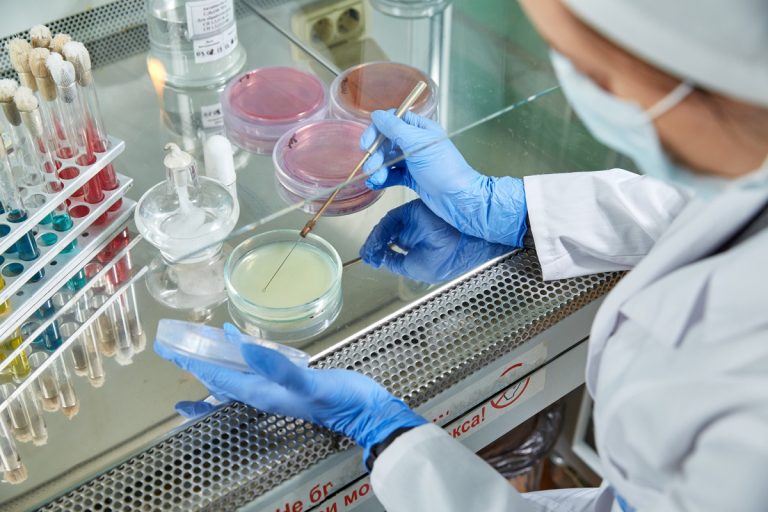
Кишечную палочку обнаружили в мясной продукции, выпускаемой в Тверской области Кишечную палочку обнаружили в мясной продукции, выпускаемой в Тверской области

Отбор продукции осуществлялся непосредственно на предприятии.
Бактерии группы кишечной палочки выявлены специалистами Тверской испытательной лаборатории ФГБУ «ВНИИЗЖ» в мясной продукции, выпускаемой одним из предприятий Верхневолжья.
Лабораторную проверку на соответствие микробиологическим нормам не прошел образец копчено-вареной свиной рульки, отобранный непосредственно на предприятии.
«Присутствие бактерий группы кишечной палочки в продукции является маркером неудовлетворительного санитарного состояния производства и низкого качества самих продуктов. Бактериальное загрязнение может быть следствием проблем с гигиеной персонала, уборкой производственных помещений или дезинфекцией оборудования»,
— сообщили в ведомстве.
Информация о выявлении БГКП направлена в Управление Россельхознадзора по Тверской и Ярославской областям для принятия правовых мер реагирования.